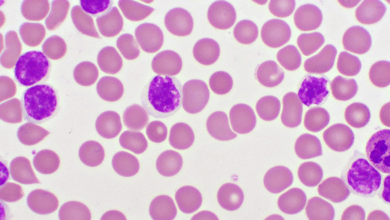

Nigerian govt flags off $950m Makurdi–9th Mile dualization project

The Federal Government on Saturday, September 13, 2025, flagged off the second phase of the Makurdi–9th Mile dualization project, a 260-kilometer highway expected to transform transportation and commerce across the North-Central and Southeast corridors.
The project, estimated at $950 million and funded by the China Exim Bank, covers 520 kilometers in dual carriage terms and is considered one of the largest legacy road projects under the Bola Ahmed Tinubu administration.
Speaking at the event in Makurdi, the Minister of Works, Engr. Dave Umahi, described the project as a major milestone that would stimulate economic activities in Benue, Enugu, and neighboring states.
“The flyover at Wurukum was not in the original design but has been added as a special gift from Mr. President to the people of Benue. This dualization will serve as a catalyst for economic revolution across the region, and we are committed to delivering it with the best quality and on time,” Umahi said.
Governor Hyacinth Alia, who represented President Tinubu, called the dualization a “game changer” that would enhance trade, agriculture, and connectivity.
He stressed that the road links the Northeast with the South-South and Southeast, making it a lifeline for farmers and businesses.
“Farmers will now be able to move their produce, including perishable goods, from Benue to Abuja and beyond without the heavy losses we see today,” Governor Alia said, while expressing gratitude to the president for what he described as “one of many gifts” to Benue within two years.
Providing technical details, Engr. Adam Onundi, Managing Director of Yolas Consultants Ltd, said the project is divided into five sections totaling 250.6 kilometers, with an additional 15.8-kilometer Lafia Bypass.
The Wurukum Flyover, which marks the start of Section One, is designed to ease Makurdi’s notorious traffic congestion.
On his part, Mr. Wang, Project Manager of China Harbour Construction Company, assured of high-quality delivery, noting that the company’s strategy was to work on all sections simultaneously for faster completion.
“With support from the federal and state governments on compensation and land acquisition, we are confident of delivering the major works before the next election,” Wang pledged.
The broader dualization project is expected to boost regional trade, unlock Benue’s agricultural potential, and ease movement across key economic corridors.
Governor Alia later accompanied the Works Minister on inspection of other projects in Makurdi, including the Makurdi–Gboko road and the Highlevel underpass.